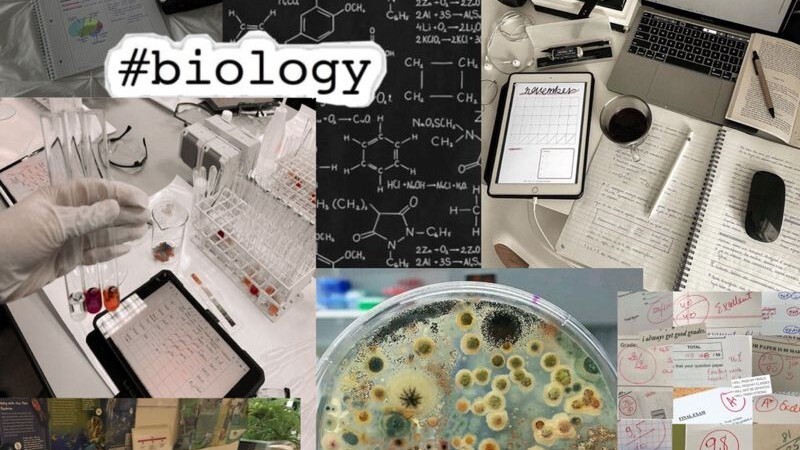

Тесты на знания
🧬 Генетика: правда или ложь?
✧ Генетика – это довольно молодая наука, которая с самого своего появления привлекает внимание людей по всему миру. Это наука, позволяющая лучше понять многие аспекты человеческой жизни, но в то же время окруженная множеством мифов и ложных домыслов.
✧ Я изучаю генетику уже на протяжении нескольких лет, и вот наконец решила посвятить этой замечательной науке целый тест. Здесь я собрала как реальные факты, так и известные мифы. Сможете ли вы отличить истину от вымысла? Приятного прохождения! 🍀
✧ Я изучаю генетику уже на протяжении нескольких лет, и вот наконец решила посвятить этой замечательной науке целый тест. Здесь я собрала как реальные факты, так и известные мифы. Сможете ли вы отличить истину от вымысла? Приятного прохождения! 🍀
Вопрос 1.
🧬 Во всех ядрах человеческих клеток, кроме половых, находится одинаковый набор ДНК...
Вопрос 2.

🧬 Гены определяют только внешность, они никак не влияют на характер...
Вопрос 3.

🧬 У человека половые хромосомы XY у мужчин и XX у женщин, а у страусов – наоборот...
Вопрос 4.

🧬 Трехцветный окрас может быть только у кошек, коты с таким окрасом не рождаются...
Вопрос 5.

🧬 Мутации в генах – страшное и опасное явление, которое всячески пытаются предотвращать...
Вопрос 6.

🧬 Продукты с надписью «ГМО» безопасны для здоровья человека, как и обычные продукты...
Вопрос 7.

🧬 Аббревиатура ДНК расшифровывается как «двойной наследственный код»...
Вопрос 8.

🧬 У людей с рыжими волосами болевой порог выше, чем у остальных...
Вопрос 9.

🧬 У человека есть «ген лени», отвечающий за трудолюбие...
Вопрос 10.

🧬 Гены нельзя редактировать, они неизменны от рождения...
Вопрос 11.

🧬 Чистопородные кошки и собаки не болеют наследственными болезнями...
Вопрос 12.

🧬 Митохондриальная ДНК передается потомкам только от матери...
Вопрос 13.

🧬 Цвет волос у людей полностью определяется одним геном...
Вопрос 14.

🧬 Генномодифицированные коровы могут давать молоко без лактозы...
Вопрос 15.

🧬 Изменения, полученные при жизни (накачанные мышцы, шрамы), не передаются по наследству...
Вопрос 16.

🧬 Гены самого первого мужа женщины передаются ее детям даже спустя годы...
Вопрос 17.

🧬 У всех домашних пород лошадей одинаковое число хромосом...
Вопрос 18.

🧬 ДНК – это, по сути, кислота...



На большинство вопросов метод тыка, и 11 баллов
Классный тест!
+3, мне очень понравилось, очень красивый, продуманный, интересный тест! Побольше бы таких на сайте. Люблю генетику, хочу стать врачом, но увы ответила лишь на 14/18
Удачи автору!
+♡♡♡
Вы набрали 9 баллов из 18.
🔬 Неплохой результат! 🧪
~~~
Очень интересно было проходить, +

@3009lada, @crystal27, @nina_29, @olgglo, @teenager, @pirate01, @murusia, @alvina, @89226360088qwerty, @varna2006yandex-ru, @doublebook, @vadaaddams, спасибо за ваши оценки и комментарии! 🩵
КЛАССНО
+3
Вы набрали 15 баллов из 18.
🔬 Почти идеальный результат!
~~~~~
Вот для чего я в вузе сдавала экзамен по генетика вххахах
О некоторых моментах я не знала, очень интересный тест ❤️
Вы набрали 10 баллов из 18.
🔬 Неплохой результат! 🧪
✧ Вы смогли набрать как минимум половину верных ответов – это хороший результат для тех, кто никогда не изучал генетику на профессиональном уровне. Но все же вам есть куда развиваться, так что скорее изучайте верные ответы ⏬
+ 3 💙 ~
Интересный тест, некоторые факты я даже не знала…
10 из 18
Вы смогли набрать как минимум половину верных ответов – это хороший результат для тех, кто никогда не изучал генетику на профессиональном уровне. Но все же вам есть куда развиваться.
***
Темы по генетике (а также задачки) были моими любимыми на школьных уроках биологии. Дальше них я, увы, не заглядывала. Что-то из теста я знала, о чем-то догадывалась в процессе.
Тест очень понравился. Видно проделанную автором работу, а также интерес к освещенной теме. Отдельное спасибо не просто за правильные ответы в результате, а за пояснения к ним, было интересно почитать.
Определенно, +3
Вы набрали 10 баллов из 18.
🔬 Неплохой результат! 🧪
~~~~
Интересный и познавательный тест в несложной форме. И красивые коллажи. +3
Вы набрали 11 баллов из 18.

🔬 Неплохой результат! 🧪
✧ Вы смогли набрать как минимум половину верных ответов – это хороший результат для тех, кто никогда не изучал генетику на профессиональном уровне. Но все же вам есть куда развиваться, так что скорее изучайте верные ответы ⏬
————
+
🔬 Слабый результат 🧪
+3
Ну это было ожидаемо, для меня тест сложный, но интересный. Очень красивые картинки и оформление теста
Вы набрали 12 баллов из 18.
🔬 Похвальный результат! 🧪
✧ Возможно, вы не изучаете генетику углублeнно, но вы явно хорошо разбираетесь в биологии и умеете логически мыслить. Ну или вы просто очень начитанный и эрудированный человек. Ваш результат в любом случае очень достойный ♡(>ᴗ•)
Очень интересный тест! Кое-что я с биологии знала, но большинство фактов для меня новые
+3
Вы набрали 13 баллов из 18.
🔬 Похвальный результат! 🧪
—
ого, думала, всё будет неправильно
похоже, даже несмотря на то, что я ничего не слушаю на уроках, в голове что-то остаётся
даже настроение поднялось, спасибо за тест
+3 🧬
Вы набрали 8 баллов из 18.
🔬 Неплохой результат! 🧪
✧ Вы смогли набрать как минимум половину верных ответов – это хороший результат для тех, кто никогда не изучал генетику на профессиональном уровне. Но все же вам есть куда развиваться, так что скорее изучайте верные ответы
Вы набрали 10 баллов из 18.
🔬 Неплохой результат! 🧪
~~~
Почаще бы таких тестов! Пару вещей я первый раз услышала, например про трехцветных котов)
Конечно +3
Вы набрали 11 баллов из 18.
🔬 Неплохой результат! 🧪
✧ Вы смогли набрать как минимум половину верных ответов – это хороший результат для тех, кто никогда не изучал генетику на профессиональном уровне. Но все же вам есть куда развиваться, так что скорее изучайте верные ответы ⏬
~~~
+🧬🧬🧬, так и думала, что это Твой тест))) Как всегда — замечательно!